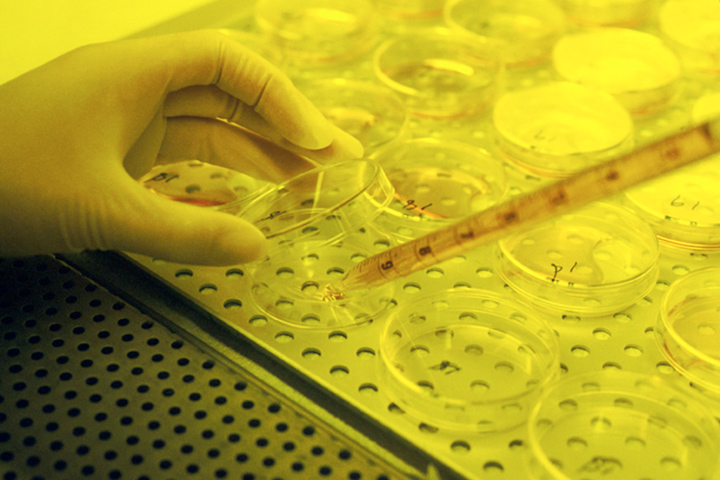

La investigación contra el cáncer de páncreas suele desarrollarse lejos del reflector público. Sin embargo, algunos avances rompen ese silencio y colocan el tema en la conversación internacional. Ese fue el caso de un estudio reciente que consiguió eliminar tumores pancreáticos en modelos animales, un resultado que atrajo atención inmediata y abrió expectativas que requieren matices.
El trabajo estuvo liderado por Mariano Barbacid y su equipo del Centro Nacional de Investigaciones Oncológicas. En los ensayos con ratones, los investigadores observaron una respuesta completa y sostenida frente al cáncer de páncreas, sin señales de resistencia durante varios meses de seguimiento.
Los propios autores han sido claros en sus alcances. El avance aún no es aplicable en pacientes humanos. Se trata de una fase preclínica, lo que implica que el proceso debe superar nuevas validaciones antes de avanzar. Para ello, advierten, será indispensable tiempo y financiamiento suficiente que permita trasladar estos resultados del laboratorio a la clínica.
Por Qué El Avance Aún No Llega A Humanos
En ciencia médica, un resultado positivo no garantiza continuidad automática. Pasar de ratones a humanos implica procesos largos y costosos. Se requiere cumplir normas estrictas de seguridad y regulación.
En el caso del cáncer de páncreas, la dificultad es mayor. Se trata de una enfermedad altamente heterogénea. Cada tumor puede responder de forma distinta. Por eso, antes de cualquier ensayo clínico, es necesario repetir los resultados en otros modelos.
El propio CNIO explicó que deben evaluarse variables genéticas y biológicas adicionales. Solo así se reduce el riesgo de fallos posteriores. Este trabajo previo es indispensable para proteger a futuros pacientes.
El equipo recurrió al apoyo público mediante la Fundación CRIS Contra el Cáncer. El objetivo es claro. Evitar que el avance quede detenido en el laboratorio por falta de recursos.
Qué Se Descubrió En Los Modelos Animales
El estudio de Barbacid se basó en una terapia combinada. Ataca tres rutas clave que los tumores de páncreas utilizan para crecer y evadir tratamientos. El enfoque bloquea simultáneamente KRAS, EGFR y STAT3.
La relevancia de KRAS es ampliamente conocida. Más del 90 por ciento de estos tumores presenta mutaciones en ese gen, según el National Cancer Institute. Durante décadas, fue considerado un objetivo casi imposible de tratar.
El valor del enfoque está en la combinación. Muchos tratamientos fallan porque el tumor activa rutas alternativas. En los experimentos, la terapia logró evitar ese mecanismo de escape. Los tumores no reaparecieron durante más de 200 días en ratones.
Los investigadores tampoco detectaron toxicidad grave. Ese dato es relevante, aunque no definitivo. La seguridad debe confirmarse en fases posteriores antes de pensar en humanos.
Para Qué Se Necesita El Financiamiento
En oncología, cada fase tiene costos específicos. Primero, deben reproducirse los resultados en otros modelos animales. La ciencia exige confirmación independiente.
Se evalúa la seguridad. Aunque no haya efectos graves en ratones, las dosis y combinaciones deben ajustarse. Pequeños cambios pueden modificar por completo la respuesta biológica.
También es necesario optimizar esquemas de tratamiento. Definir cuánto medicamento usar y durante cuánto tiempo. Estas decisiones se toman con datos adicionales.
Se prepara el ensayo clínico. Esto incluye permisos éticos, fabricación de fármacos bajo estándares clínicos y monitoreo constante. Por eso, las inversiones suelen ser millonarias.
De acuerdo con información difundida en medios europeos, el salto a ensayos en humanos requeriría menos de 30 millones de euros. Además, se necesitarían al menos dos o tres años más de trabajo.
Qué Ocurre Si La Investigación Se Detiene
Cuando un proyecto se frena por falta de recursos, las consecuencias van más allá del retraso. Se pierde impulso científico. Los equipos se fragmentan. Las colaboraciones se debilitan.
En los últimos años, centros como MD Anderson, el NCI o Memorial Sloan Kettering han presentado avances similares. Inmunoterapia, vacunas de mRNA y detección temprana forman parte del nuevo panorama. Todos comparten un punto en común. Requieren financiamiento sostenido.
El cáncer de páncreas sigue siendo uno de los más agresivos. Su diagnóstico suele ser tardío. La tasa de supervivencia a cinco años es inferior al 12 por ciento, según la Organización Mundial de la Salud.
El Valor Del Apoyo Científico A Largo Plazo
El caso del equipo del CNIO refleja un problema global. La ciencia ya identifica mejor los puntos débiles del cáncer de páncreas. Sin embargo, recorrer el camino hasta el hospital exige recursos.
Apoyar este tipo de investigación no significa creer en curas milagro. Significa sostener procesos rigurosos. Si el financiamiento llega, el equipo podría preparar el salto a humanos en los próximos años. Para los pacientes, ese tiempo sigue siendo enorme. Para la ciencia, es una ventana realista.
En una enfermedad con uno de los pronósticos más difíciles, cada paso sostenido puede marcar la diferencia en el futuro.
Array